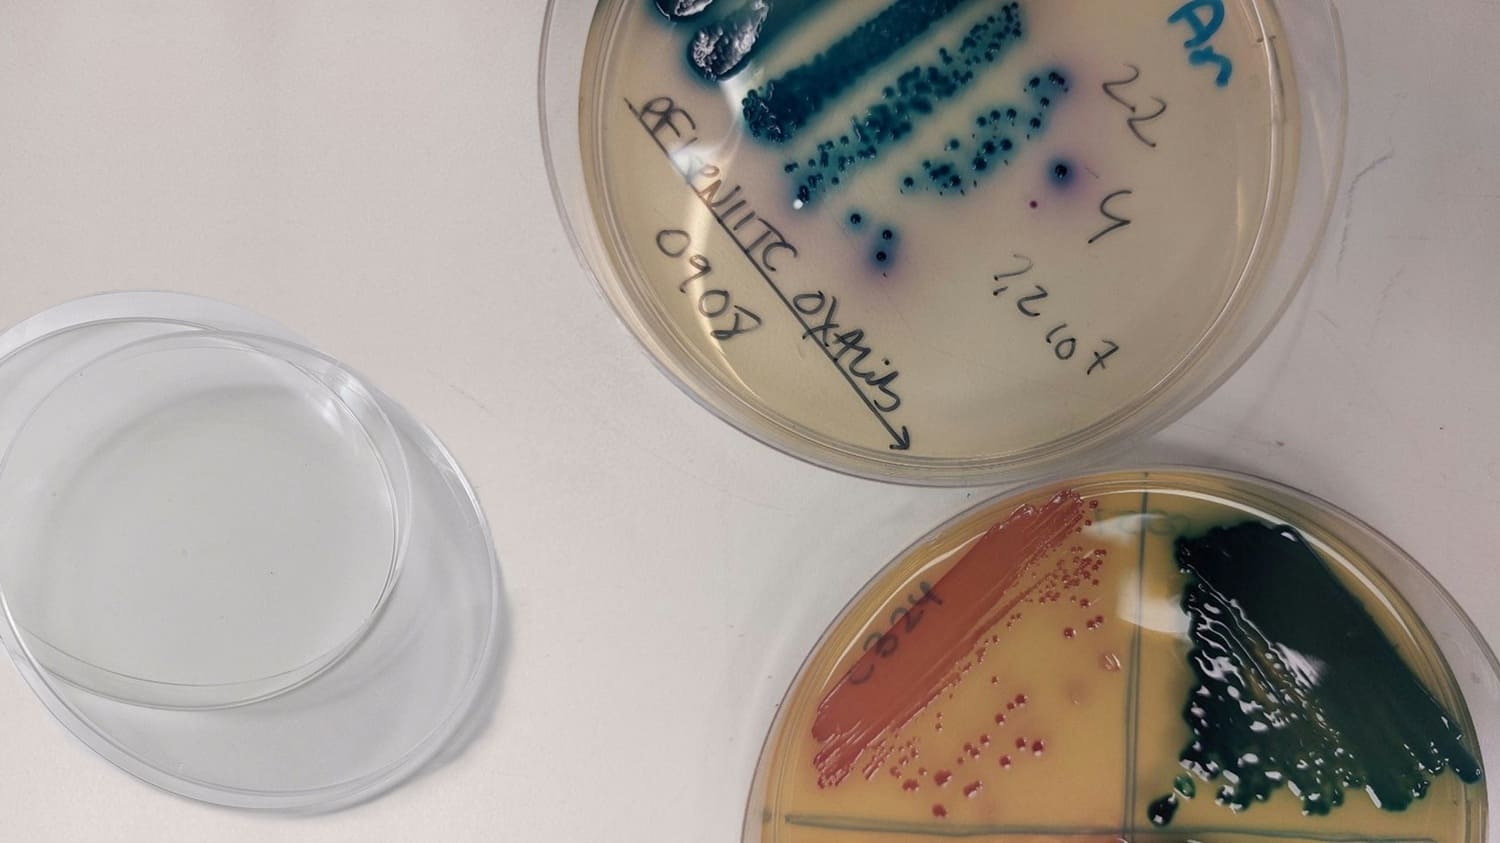

Escuchar esta nota
Detenido
Octubre, 2025
Un informe de la Organización Mundial de la Salud revela que entre 2018 y 2023 la resistencia a los antimicrobianos de uso habitual ha aumentado en más del 40 %. La institución llama a los países miembro a fortalecer sus medidas de vigilancia de uso de estos medicamentos.
Los antibióticos se consideran uno de los avances más importantes en la historia de la medicina. Su introducción en la práctica clínica durante la década de 1940 marcó un hito en el control de las enfermedades infecciosas, mejoró la salud humana y prolongó la esperanza de vida.
Hoy, paradójicamente, el impacto de la resistencia bacteriana a los antibióticos se ha convertido en una amenaza global y un gran desafío para la medicina actual. Su uso extensivo, y a menudo indiscriminado, en medicina, veterinaria y agricultura ha generado condiciones favorables para la selección de bacterias resistentes.
De acuerdo a un nuevo informe de la Organización Mundial de la Salud (OMS), una de cada seis infecciones bacterianas diagnosticadas en 2023 fue resistente a los tratamientos con antibióticos.
El texto recalca que, entre 2018 y 2023, la resistencia a los antibióticos aumentó en más del 40 %, con un incremento anual medio de entre el 5 % y el 15 %.
Los datos comunicados al Sistema Mundial de Vigilancia de la Resistencia a los Antimicrobianos y de su Uso (GLASS, por sus siglas en inglés) de la OMS, por más de 100 países, son una advertencia de que el aumento de la resistencia a los antibióticos esenciales constituye una amenaza creciente para la salud mundial.
En el nuevo “Informe mundial sobre la vigilancia de la resistencia a los antibióticos 2025” se presentan, por primera vez, estimaciones de la prevalencia de la resistencia en 22 antibióticos utilizados para tratar infecciones urinarias y gastrointestinales, en el torrente sanguíneo y la gonorrea.
Se tratan ocho patógenos bacterianos frecuentes —Acinetobacter spp., Escherichia coli, Klebsiella pneumoniae, Salmonella spp. no tifoidea, Neisseria gonorrhoeae, Shigella spp., Staphylococcus aureus y Streptococcus pneumoniae— cada uno relacionado con una o más de dichas infecciones.
El riesgo varía de un país a otro
La OMS señala que la mayor resistencia a los antibióticos se registra en la región de Asia Sudoriental y la del Mediterráneo Oriental, donde una de cada tres infecciones notificadas era resistente. A ellas le sigue África, en la que una de cada cinco infecciones era resistente.
De acuerdo a la organización internacional, la resistencia también es más habitual y se agrava donde los sistemas de salud carecen de capacidad para diagnosticar o tratar patógenos bacterianos.
Tedros Adhanom, director de la OMS, ha sido claro: “La resistencia a los antimicrobianos va más rápida que los avances en la medicina moderna, con la consiguiente amenaza para la salud de las familias en todo el mundo”, ha declarado.
“A medida que los países fortalecen sus sistemas de vigilancia, debemos usar los antibióticos de forma responsable y asegurarnos de que todas las personas tengan acceso a los medicamentos, medios de diagnóstico de calidad garantizada y vacunas adecuados. Nuestro futuro también depende del fortalecimiento de los sistemas para prevenir, diagnosticar y tratar infecciones y de la innovación con antibióticos de nueva generación y pruebas moleculares rápidas en el lugar donde se presta la atención”.

Bacterias gramnegativas, la mayor amenaza
En el nuevo informe se señala que las bacterias gramnegativas farmacorresistentes son cada vez más peligrosas a escala mundial, sobre todo en los países menos equipados para hacerles frente. Entre ellas, E. coli y K. pneumoniae son las principales bacterias gramnegativas farmacorresistentes detectadas en las infecciones sanguíneas.
Estas son las infecciones bacterianas más graves y con frecuencia desembocan en sepsis, insuficiencia orgánica e incluso la muerte. Sin embargo, más del 40 % de las infecciones mundiales por E. coli y del 55 % por K. pneumoniae son resistentes actualmente a las cefalosporinas de tercera generación, el tratamiento de primera elección para esas infecciones. En la Región de África, la resistencia incluso supera el 70 %.
Otros antibióticos esenciales, gracias a los que se salvan muchas vidas, como los carbapenémicos y las fluoroquinolonas, son cada vez menos eficaces contra E. coli, K. pneumoniae, Salmonella y Acinetobacter.
De hecho, señala el informe, la resistencia a los carbapenémicos, que solía ser rara, es cada vez más frecuente, lo que reduce las opciones terapéuticas y obliga a recurrir a antibióticos de último recurso. Y estos antibióticos son costosos, de difícil acceso y en muchas ocasiones no están disponibles en los países de ingreso bajo y mediano.
Se necesitan más medidas de vigilancia
El número de países que participan en el sistema de vigilancia GLASS se ha cuadruplicado, de 25 países en 2016 a 104 en 2023. Sin embargo, el 48 % de ellos no notificaron datos al GLASS en 2023 y aproximadamente la mitad de los países notificantes seguían sin tener sistemas para generar datos fiables. De hecho, los países que se enfrentan a las mayores dificultades carecen de capacidad de vigilancia para evaluar su situación en materia de resistencia a los antimicrobianos.
La OMS hace un llamamiento a todos los países para que comuniquen al GLASS datos de calidad sobre la resistencia antimicrobiana y el uso de los antibióticos a más tardar en 2030. Alcanzar esta meta requerirá adoptar medidas concertadas para reforzar la calidad, la cobertura geográfica y el intercambio de datos sobre la vigilancia, a fin de hacer seguimiento de los progresos.
Los países deberían ampliar las intervenciones coordinadas concebidas para hacer frente a la resistencia a los antimicrobianos en todos los niveles de la atención de salud y garantizar que las directrices terapéuticas y las listas de medicamentos esenciales estén alineadas con los patrones locales de resistencia.
Como señala Trent Yarwood, médico especialista en enfermedades infecciosas y miembro de la Sociedad Australiana de Enfermedades Infecciosas, en declaraciones para Science Media Centre:
“Todo el mundo puede hacer algo para combatir la resistencia a los medicamentos. Por ejemplo, prevenir las infecciones lavándose las manos, vacunándose y practicando buena seguridad alimentaria. Tome antibióticos sólo cuando sean necesarios y durante el tiempo recomendado por su médico. El informe destaca que todos estamos conectados, por lo que el mundo debe trabajar conjuntamente para ayudar a resolver el problema”. ![]() (Con información de la OMS)
(Con información de la OMS)